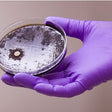

Bastion | SKU:
340533
Nitrile Gloves - Powder Free - Purple - Micro Textured
Please sign in to request a quote.
$33.00 AUD
Unit price
/
Unavailable
Shipping calculated at checkout.
Nitrile Gloves - Powder Free - Purple - Micro Textured - Nitrile Gloves - Powder Free - Purple - Micro Textured - M is backordered and will ship as soon as it is back in stock.
Couldn't load pickup availability
Description
Description
Payment & Security
Payment methods
Your payment information is processed securely. We do not store credit card details nor have access to your credit card information.